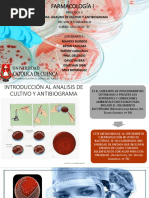

EL CICLO BIOENERGTICO EN EL CUERPO
De acuerdo con la MTC, el ki (energa) fluye durante el da por el cuerpo en un orden determinado, configurando un verdadero reloj bioenergtico, que debemo conocer y manejar a la perfecci!n para determinar el momento adecuado para la accione teraputica a que "aya lugar# $l Reloj Chino del diagrama anterior repre enta el recorrido del ki a u pa o por lo canale en el tra cur o del da# $l ki atravie a !rgano yin y yang por pareja # Como e ve el Canal %ulmonar (yin) "ace pareja con el canal del &nte tino 'rue o (yang), y a uce ivamente# Cada pareja de !rgano yin y yang pertenece al mi mo elemento# Cada canal tiene una m()ima actividad que dura do (*) "ora y una fa e de actividad mnima +* "ora m( tarde# $l ciclo empie,a con el canal pulmonar (de - a . am), aparece en el pec"o e)terior, y igue luego una ecuencia continua que termina en el "gado de de donde el ki vuelve a tomar el canal pulmonar para reiniciar otra ve, el ciclo %or e o e muy ignificativo ob ervar la "ora del da en que aparecen lo ntoma porque e o puede indicar cu(l e el canal que e t( en de armona# $l i tema tambin e/ala la "ora adecuada para la terapia teniendo en cuenta lo iguiente0 Cuando aplicamo polaridad po itiva a un punto, tonificamo la energa propia del !rgano y edamo la del !rgano opue to en la circulaci!n ya de crita (cuando un !rgano e t( al m()imo, el opue to e t( al mnimo)# $jemplo0 i aplicamo polaridad 1 en el punto %2 (punto "orario del %ulm!n) damo m( energa al %ulm!n y edamo la energa de la 3ejiga ( u !rgano opue to)# $n cambio i aplicamo polaridad 4 al mi mo punto %2 edamo la energa del %ulm!n y fortalecemo la energa de la 3ejiga ( u !rgano opue to)# 5i por cue ti!n "oraria e difcil tratar un !rgano a la "ora de u m()ima energa, e podr( "acer lo contrario a la "ora de m()ima energa del !rgano opue to# 6 , i e tamo frente a un 7gado que "ay que tonificarlo, tendramo que aplicarle polaridad 1 entre la + y la - de la ma/ana# $ una "ora difcil, por lo que tendramo que pen ar en trabajar obre el !rgano contrario, en e te ca o el &nte tino Delgado entre la + y la - de la tarde# Como el objetivo e tonificar al "gado entonce edamo al inte tino delgado (4)# 8$59M$:0 $l punto "orario eda o tonifica el energa propia del !rgano a e)pen a del tonificar o edar la energa propia del !rgano opue to#
�EXPLICACIN DE CADA PUNTO DE MAYOR ENERGIA 7;860 + < - 6M 0 7gado (7+) =ocali,aci!n0 6 >,+ cun lateralmente del (ngulo ungueal e)terno del dedo gordo del pi# ?9:C&;:$50 De conge tiona el "gado y ordena la energa, regula el flujo men trual, movili,a el agua# 6cci!n equilibradora y reguladora de la va urinaria , retenci!n e incontinencia urinaria# $limina "umedad y calor, uavi,a y de bloquea la energa del 7gado#
7;86 0 -4 . 6M %9=M;: (%2) =ocali,aci!n0 6 + cun por encima del pliegue tran ver al de la mu/eca, en la depre i!n obre el lado radial de la arteria radial# ?9:C&;:$50 To , a ma, dolor en el pec"o, dolor de garganta, dolor en la mu/eca y en la mano#
7;860 .4@ 6M# &:T$5T&:; '89$5; (&'+) =ocali,aci!n0 $n el lado radial del dedo ndice# 6 >,+ cun po terior al lado ungueal# ?9:C&;:$5 Calma la mente# Dolore en el cuello, en la garganta, conjuntiviti 6bre el cerebro (conocido tambin como Aorificio
�puroB), por e o e recomendado para conciencia en ca o de emergencia
re taurar la
7;860 @4C 6M# $5T;M6'; ($-D) =ocali,aci!n0 6 - cun por debajo del borde inferior de la r!tula y un dedo tran ver al "acia fuera del borde anterior de la tibia# ?9:C&;:$50 $ te punto fortalece el i tema defen ivo y refuer,a la inmunidad ya que corrige la perturbacione de la energa defen iva (Eei)# =a energa defen iva (o ki defen ivo) circula por lo !rgano y v cera para defenderlo , protegiendo de e ta manera al organi mo contra la inva i!n de elemento pat!geno e)tra/o y contra la tentativa de modificaci!n de la e tructura ti ular u org(nica# $ te punto tiene efecto tonificante y e un importante Fdador de aludF 7;860 C4++ 6M# G6H;4%6:C8$65 (G%-)# =ocali,aci!n0 $n la parte po teroinferior del primer metatar iano, en la uni!n de la carne blanca y roja# %unto fuente# ?9:C&;:$50 8efuer,a el ba,o y armoni,a al e t!mago aport(ndole "umedad ya que e te Iltimo ufre con iderablemente con la equedad y el calor# 5i lo fluido del e t!mago on deficiente la dige ti!n e ve afectada# %or e o e te punto e ideal para lo ca o de falta de apetito y toda la patologa dige tiva # Da claridad mental y fortalece la memoria# 8ecomendable en ca o de pen amiento confu o #
7;860 ++6M 4+%M# C;86H;: (C2)# =ocali,aci!n0 $ntre el cuarto
el
quinto
�metacarpiano, en la palma de la mano, a nivel de 2 MC# ?9:C&;:$50 5e dice que e te punto aclara el cora,!n, ya que a trav de l podemo "acerle frente a muc"o problema emocionale y mentale , como intranquilidad o an iedad, nervio i mo, in omnio, pe adilla e irritabilidad# $n la labilidad p icoemocional (cambio bru co en la emocione , e pa a de la ri a al llanto o vicever a, por ejemplo)# Como e ve e un punto muy cercano a lo emocional # 7;860 +4 - %M# &:T$5T&:; D$='6D; (&D.)# =ocali,aci!n0 $n el e)tremo del lado cubital del pliegue tran ver al del dor o de la mu/eca, en la depre i!n anterior del cIbito# ?9:C&;:$50 Cefalea, dolor de cabe,a, vrtigo, tinitu , ordera, enfermedade febrile , fiebre, dolor en la mu/eca# Como la energa del canal del inte tino delgado e t( ligada el cora,!n contribuye a la claridad de la mente, por e o e te punto e recomendable para p ico i maniaco depre iva, mana, epilep ia# $leva la energa b( ica# 7;860 -4. %M# 3$J&'6 (3DD) =ocali,aci!n0 $ t( en la parte anteroinferior de la quinta articulaci!n metatar ofal(ngica, entre la piel blanca y la roja# ?9:C&;:$5 =ibera la fuer,a e piritual y calma el dolor# Tra torno manaco4depre ivo , tra torno amn ico , prdida de memoria# Calma la emotividad, el nervio i mo#
7;860 .4@ %M < 8&KL: (8+>) =ocali,aci!n0 5e "alla ituado en el lado interno
�de la ,ona popltea, entre lo tendone de lo mI culo emitendino o y emimembrano o cuando la rodilla e t( fle)ionada# ?9:C&;:$5# =o ntoma de la di funci!n del canal del ri/!n e caracteri,an por la debilidad y el decaimiento y normalmente con i ten en problema urinario y e)uale , Ilcera , dolore en la parte baja de la e palda, mala memoria, vrtigo, problema capilare y ,umbido en lo odo # %or e o e te punto e el adecuado para tratar impotencia, patologa genital y perturbacione de la micci!n#
7;860 @4C %M < %$8&C68D&; (MC2)# =ocali,aci!n0 $n el medio del pliegue tran ver al de la palma de la mano, entre el egundo y el tercer metacarpiano# ?9:C&;:$50 $ te punto, llamado por lo c"ino A%alacio del trabajoB, en medio de la palma de la mano, e t( con iderado como un importante centro del ki o de la energa# 6clara el cora,!n como centro emocional, libera la fuer,a e piritual, enfra y calma la angre# 5oluciona edema 6cci!n edante y e pa moltica en tra torno p quico y p ico om(tico # 6nti"emorr(gica en "emateme i (e)pul i!n de angre por la boca, en forma de v!mito, procedente del aparato dige tivo#) y epi ta)i (toda "emorragia con origen en la fo a na ale #)# 7emorragia anale # &nflamacione de la cavidad bucal# %unto de m()ima eficacia de MC para calmar la mente# 7;860 C4++ %M <T8&%=$ C6=$:T6D;8 (5JD)# =ocali,aci!n0 6 - cun por encima del pliegue tran ver al del dor o de la mu/eca, entre el cIbito y el radio#
�?9:C&;:$50 $l Triple Calentador o 5an Jiao, tran forma y regula lo fluido del cuerpo# $ de ayuda para la "inc"a,!n y mole tia abdominale en ca o de dificultade de orina o de e tre/imiento y en lo ca o de infeccione y fiebre # $ te punto por tanto e t( indicado para ca o de fiebre y dolore #
7;860 ++pm < +am <3$5&C9=6 G&=&68 (3GM+)# =;C6=&H6C&;: %or delante de la articulaci!n del MN y .N metatar iano, en la depre i!n que e forma en la parte e)terna del tend!n del mu culo e)ten or menor de lo dedo # ?9:C&;:$50 %unto de apertura del meridiano curio o Dai Mai# 5irve para armoni,ar la relaci!n entre el Dumai y el 8enmai, del que no ocuparemo ma adelante# Cefalea "emicraneana, "emiplejia y tra torno en oriale dolor en pie, lumbalgia# 5uavi,a la energa del "gado#
[Link]
"ttp0OOEEE#actiEeb#e Oqi omaOinde)#"tml